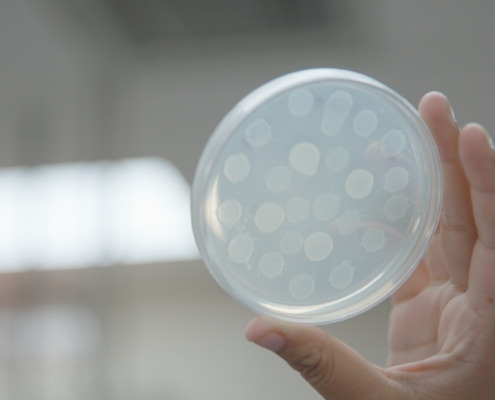

Student Research Programs
Summer Student Research 2024
Interested in participating in research during the summer? We are dedicated to providing opportunities on and off campus for students. The following links are collected to provide any kind of opportunity involving research, internships, and employment whether at Fresno State or beyond.